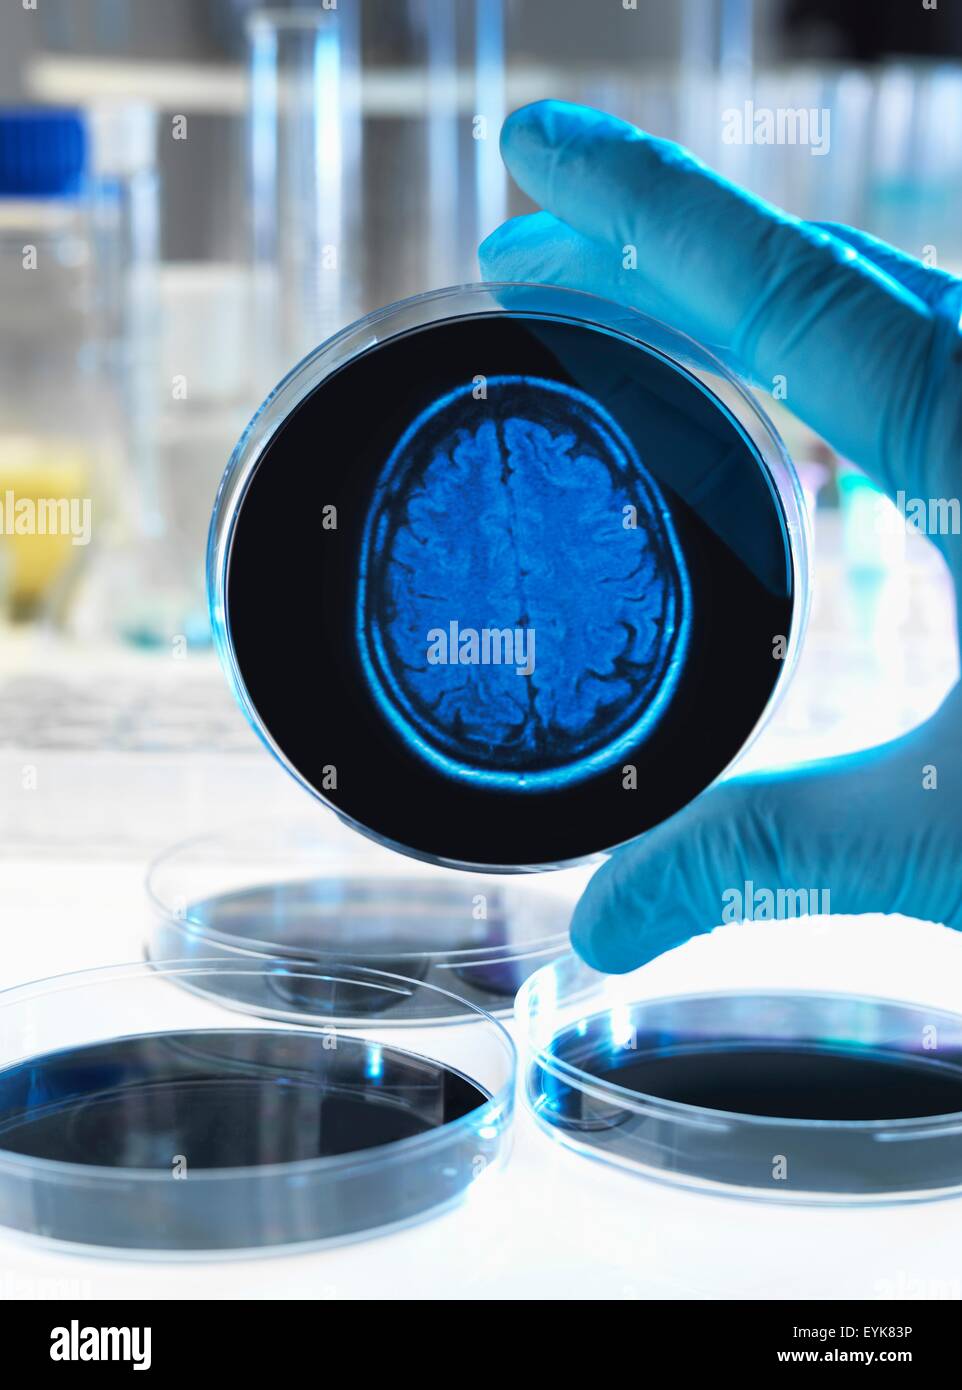
Wissenschaftler halten eine Petrischale mit einem Gehirn-Scan zur Veranschaulichung Forschung in Demenz, Alzheimer und anderen Erkrankungen des Gehirns. Stockfoto
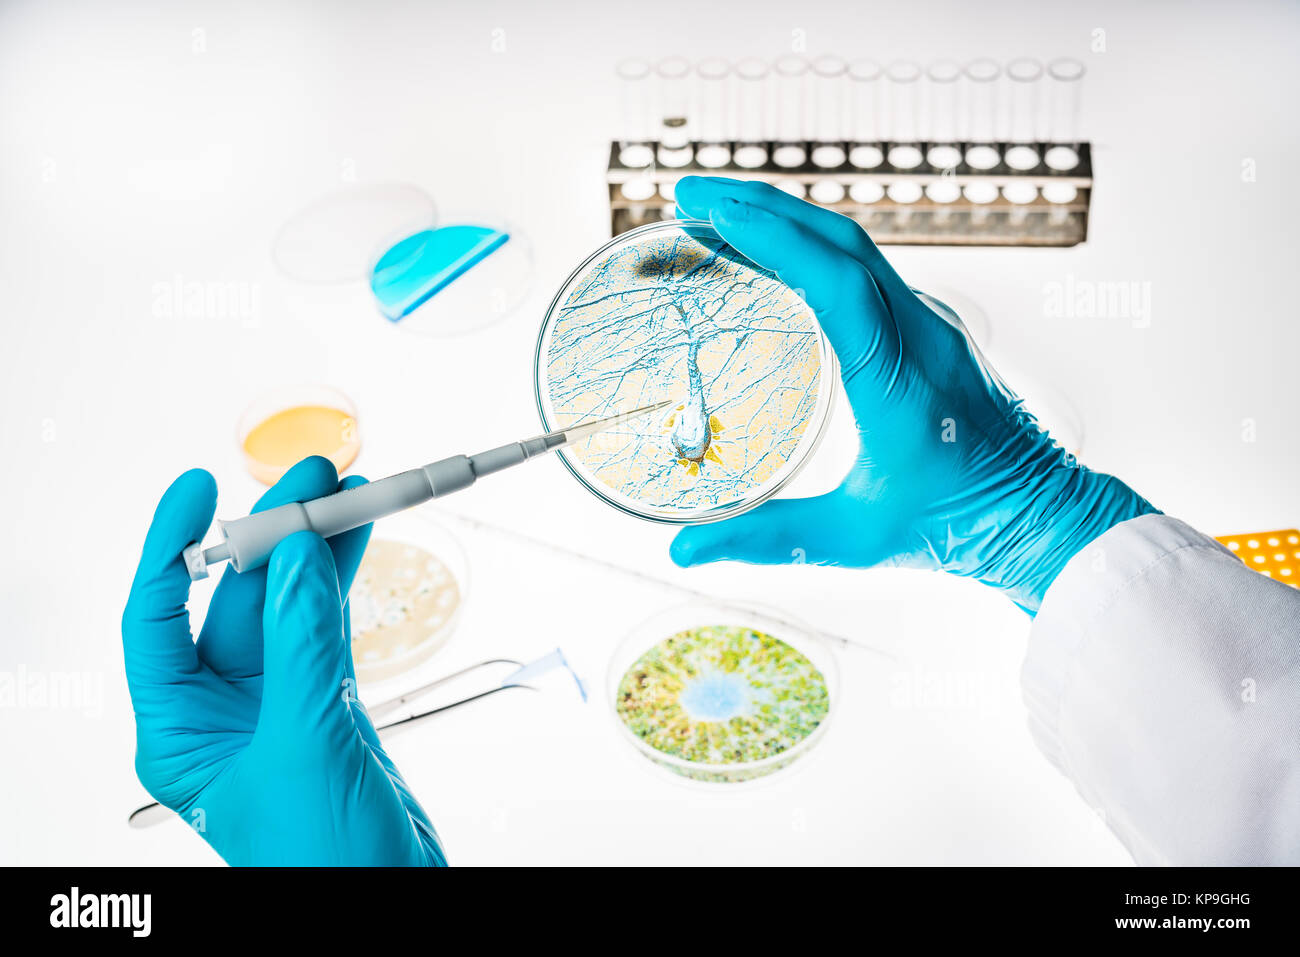
Nervenzelle in einer Petrischale, Forschung zu Alzheimer und anderen Erkrankungen des Gehirns. Stockfoto
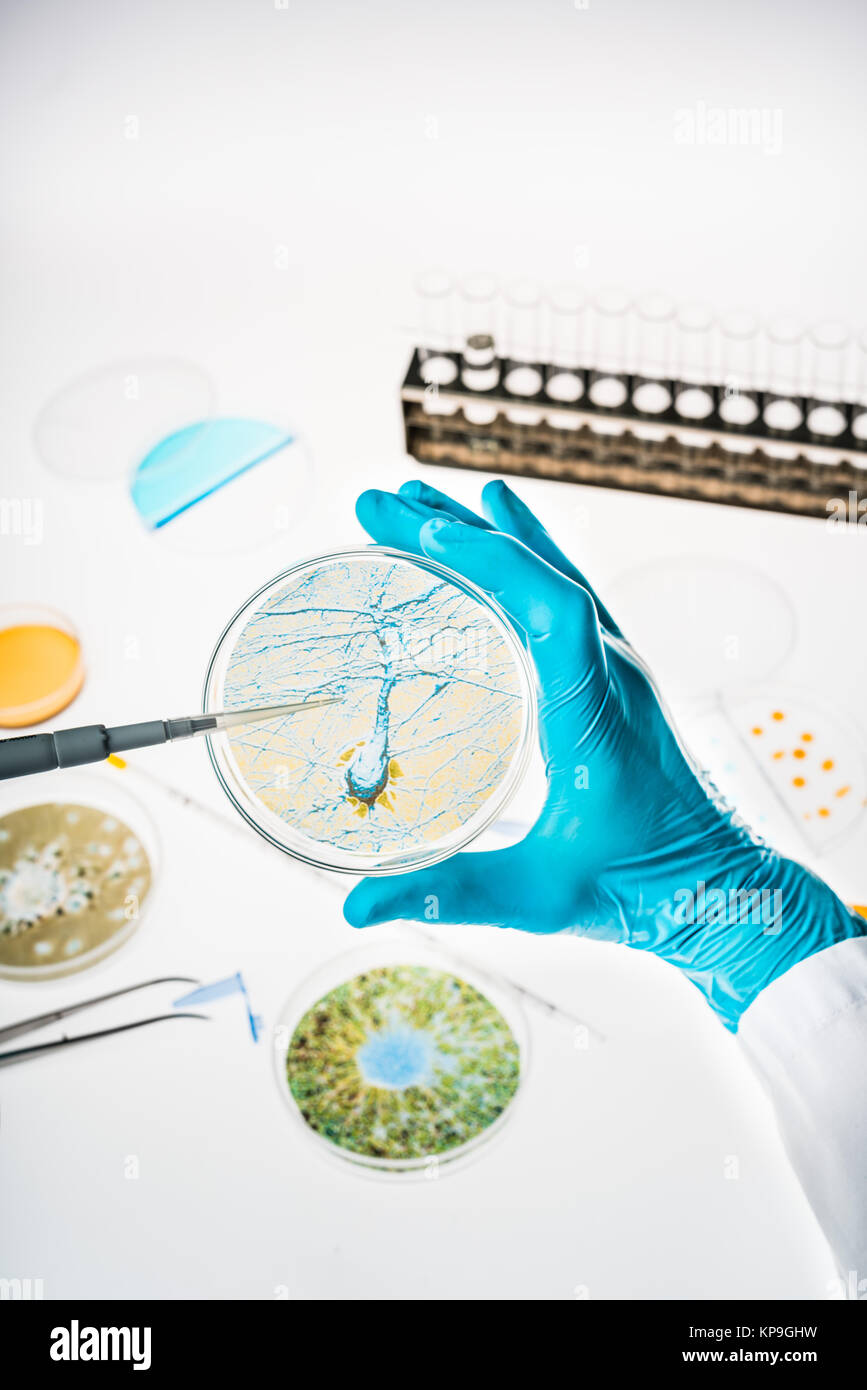
Nervenzelle in einer Petrischale, Forschung zu Alzheimer und anderen Erkrankungen des Gehirns. Stockfoto
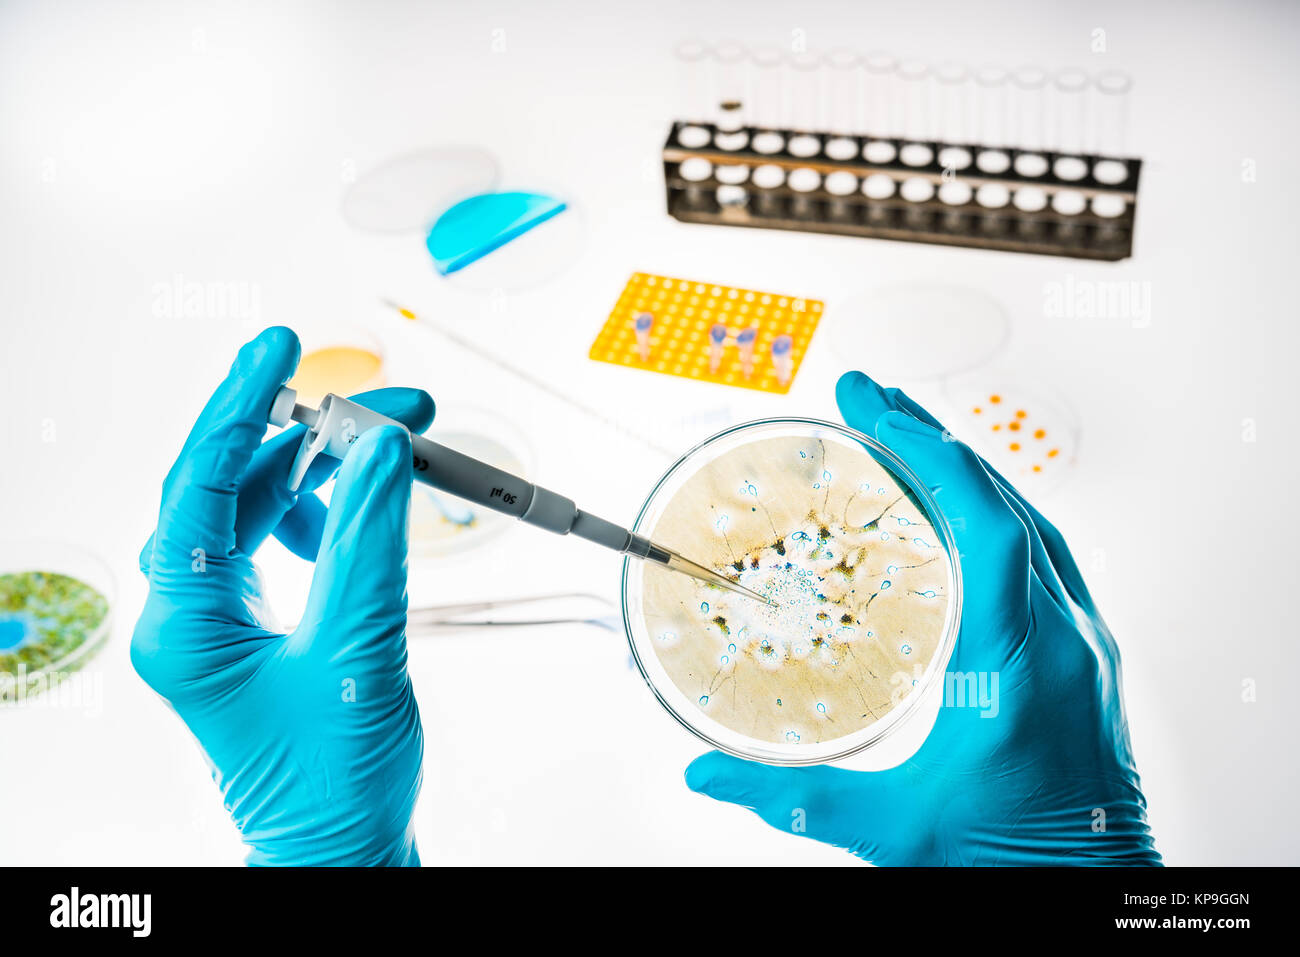
Nervenzelle in einer Petrischale, Forschung zu Alzheimer und anderen Erkrankungen des Gehirns. Stockfoto

Schnellfilter:
Erkrankungen des gehirns Stockfotos & Bilder

RF2J8T8F0–Gehirnstörungen und psychische Erkrankungen oder Psychologie und Psychiatrie Konzept als menschliches Gehirn in gebrochenen Stücken in einem 3D Illustration Stil.

RME13CMA–29. Februar 2012 - Brain Röntgenstrahlen durch Computer bewertet: Eine britische Elektronikunternehmen entwickelte sich ein Röntgensystem das es says.for das erste Mal machen die Untersuchung von Tumoren und anderen Gehirn Störungen viel präziser und Diagnose wird sehr helfen. Die Maschine, kombiniert mit einem Digitalrechner Röntgendetektoren wurde in den letzten drei Jahren von EHI. Dadurch werden wesentlich mehr Informationen als mit herkömmlichen Röntgenmethoden extrahiert werden. Tests bei 70 Patienten Atkinson Morley Hospital. Wimbledon, haben sich bewährt. Die Untersuchung dauert nur ca. 10 Minuten
RFEYK83P–Wissenschaftler halten eine Petrischale mit einem Gehirn-Scan zur Veranschaulichung Forschung in Demenz, Alzheimer und anderen Erkrankungen des Gehirns.

RFEYK83N–Wissenschaftler halten eine Petrischale mit einem Gehirn-Scan zur Veranschaulichung Forschung in Demenz, Alzheimer und anderen Erkrankungen des Gehirns.

RFRCP6A1–Symbol für die Welt Parkinson Tag. Vector Illustration. Grau awareness Ribbon, auf weißem Hintergrund. Symbol des Gehirns

RMJ2XKJ9–Carl Wernicke war ein deutscher Neurologe, bekannt für seine Arbeit über Hirnanatomie und Sprachstörungen. Seine Forschungen in Breslau legten den Grundstein für das Verständnis von Wernickeâ Bereich der Sprachverarbeitung.
RMKP9GHG–Nervenzelle in einer Petrischale, Forschung zu Alzheimer und anderen Erkrankungen des Gehirns.

RM2YADKYP–Anatomie des menschlichen Gehirns Nervensystem, Nervenkrebs, Talgkolben, Hirnkrebs Tumorwachstum und Ausbreitung maligner Zellen, Meningeom, neurologisches d

RF2X6ABBA–Eine durchgehende, einzeilige Geschäftsfrau versucht, fliegende Gehirne mit Schmetterlingsnetz zu fangen. Psychische Retardierung durch Hirnstörungen. Geisteskrankheit. Si

RF2M19N76–Geschäfts- und Finanzkonzept. Auf dem Tisch befinden sich Büroklammern und Richtungspfeile, ein Schild mit der Aufschrift "Gehirnstörungen"

RMW0H2WF–Präsident Barack Obama kündigt die Schaffung des Gehirns (das Gehirn Forschung durch die Förderung innovativer Neurotechnologies) Initiative, am 2. April 2013 im Weißen Haus in Washington, D.C. Die Initiative ist eine neue Forschung planen Sie neue Wege finden, zu behandeln, zu heilen und zu verhindern, dass Erkrankungen des Gehirns wie Alzheimer und Epilepsie. UPI/Kevin Dietsch

RMJE992T–Prof. Wilfried Heller, eine herausragende Persönlichkeit in der wissenschaftlichen Forschung, stellte am 26. November 2013 in einem Vortrag Erkenntnisse zu seiner Arbeit über neurologische Störungen vor. Seine Beiträge sind im medizinischen Bereich anerkannt, um das Verständnis von Gehirnfunktionen zu fördern.

RF2WDCTH2–Die Ärztin, Latina Neurologe, betreut männliche, brünette Patienten in ihrer Praxis, zeigt eine Röntgenaufnahme des Gehirns, um Kopfverletzungen und Gehirnerkrankungen zu beurteilen

RM2SA14XN–In einer Studie an Fliegen zeigten Wissenschaftler des NIH, dass das Immunsystem für die Schäden verantwortlich sein kann, die durch altersbedingte Störungen des Gehirns verursacht werden. Weitere Informationen:

RF2WHA1N0–Psychische Gesundheitstherapie und Neuromodulation Psychologie oder Psychiatrie Konzept mit als Puzzle-Stück Symbol als medizinische Metapher für Hirnstörungen

RF2YP3BTB–Das Stethoskop befindet sich über einem hirnförmigen Puzzle auf schwarzem Hintergrund. Illustration des Konzepts der medikamentösen Behandlung psychischer Störungen

RF2T2E9T9–Silberne Sensibilisierungsband stellt Brain Disorders Campaign for the Brain Disabled Children Brain Disabilities Parkinson's Disease Enzephalitis schizo dar

RM2SA1XFN–In einer Studie an Fliegen zeigten Wissenschaftler des NIH, dass das Immunsystem für die Schäden verantwortlich sein kann, die durch altersbedingte Störungen des Gehirns verursacht werden. Weitere Informationen: Fliegen Sie Hirnzellen 016931 014

RFRCP6B9–Symbol für die Welt Parkinson Tag. Vector Illustration. Grau awareness Ribbon, auf weißem Hintergrund. Symbol des Gehirns

RF3ATDA30–Hirn-Darm-Achse. Darmmikrobiota. Vagusnerv und enterisches Nervensystem. Vektorabbildung. Medizinisches Poster. Schematische Darstellung

RMKP9GH4–Nervenzelle in einer Petrischale, Forschung zu Alzheimer und anderen Erkrankungen des Gehirns.

RM2YADP2N–Anatomie des menschlichen Gehirns Nervensystem, Nervenkrebs, Talgkolben, Hirnkrebs Tumorwachstum und Ausbreitung maligner Zellen, Meningeom, neurologisches d

RMM05ED0–Brainans repräsentiert eine Organisation oder ein Projekt mit einem Schwerpunkt auf kognitiven Wissenschaften oder Hirnforschung, obwohl weitere Details erforderlich sind, um ihren Zweck oder Kontext zu verstehen.

RMW0H2W9–Präsident Barack Obama kündigt die Schaffung des Gehirns (das Gehirn Forschung durch die Förderung innovativer Neurotechnologies) Initiative, am 2. April 2013 im Weißen Haus in Washington, D.C. Die Initiative ist eine neue Forschung planen Sie neue Wege finden, zu behandeln, zu heilen und zu verhindern, dass Erkrankungen des Gehirns wie Alzheimer und Epilepsie. UPI/Kevin Dietsch

RM3AGRKB5–25. März 2012 - QA'em Shahr, Mazandaran, Iran - es gibt fast 90 Männer in diesem Zentrum, die an angeborenen oder zufälligen Gehirnerkrankungen leiden. Ein Großteil der Hilfe für diese Organisation wird öffentlich unterstützt. Dennoch hat die Organisation finanzielle Engpässe bei der Bereitstellung von Medikamenten und medizinischen Geräten. Zu den bemerkenswertesten Einrichtungen dieser Organisation gehören die gute Ernährung, Schlaf und Hygiene. Für diese psychisch gestörten Menschen gibt es Ausbildungszeiten wie Bildhauerei und Malerei. Die meisten von ihnen freuen sich immer auf ihre Familien und

RF2WDCTC9–Die Ärztin, Latina Neurologe, betreut männliche, brünette Patienten in ihrer Praxis, zeigt eine Röntgenaufnahme des Gehirns, um Kopfverletzungen und Gehirnerkrankungen zu beurteilen

RF2XHD43F–Community Mental Health und Gruppentherapie als Psychologie- oder Psychiatrie-Therapeutin unterstützen Sie bei Hirnstörungen oder Stimmungs- und Verhaltensstörungen.

RFTAD78P–Die pharmazeutische Forschung in Gehirn Störungen einschließlich Demenz und Alzheimer, Eppendorf Tube

RM2RM0T0H–Bildnummer: 59468038 Datum: 02.04.2013 Copyright: imago/Xinhua (130402) -- WASHINGTON D.C., 2. April 2013 (Xinhua) -- US-Präsident Barack Obama nimmt an der Ankündigung der BRAIN-Initiative (Brain Research through Advancing innovative Neurotechnologies) der Regierung Teil, die am 2. April 2013 im East Room des Weißen Hauses in Washington D.C., der Hauptstadt der Vereinigten Staaten, stattfindet. Die Initiative soll das Verständnis des menschlichen Geistes revolutionieren und soll Forschern schließlich helfen, neue Wege zur Behandlung, Heilung und sogar Vorbeugung von Hirnerkrankungen zu finden. (Xinhua/Zhang Jun) US-WAS

RFRCP6ME–Symbol für die Welt Parkinson Tag. Vector Illustration. Grau awareness Ribbon, auf weißem Hintergrund. Symbol des Gehirns

RF2WBFDX4–Ein Schraubenschlüssel auf einem roten falschen Gehirn. Das Konzept, deinen Verstand zu fixieren.
RMKP9GHW–Nervenzelle in einer Petrischale, Forschung zu Alzheimer und anderen Erkrankungen des Gehirns.

RM2YADM6C–Anatomie des menschlichen Gehirns Nervensystem, Nervenkrebs, Talgkolben, Hirnkrebs Tumorwachstum und Ausbreitung maligner Zellen, Meningeom, neurologisches d

RMJ3KNWN–Die 1892 erschienene Arbeit „Nervenkrankheiten“ von William Gowers ist ein bedeutender Beitrag zur Erforschung neurologischer Störungen. Es beschreibt verschiedene Bedingungen, die das Nervensystem beeinflussen, und hilft, die Grundlage für die moderne Neurologie zu legen.

RF2E3H6K6–Kopf-Profil mit Gehirn aus zerbrochenen Puzzle-Stücke auf weißem Hintergrund - Konzept der Hirnerkrankungen, Alzheimer, Demenz

RF2G42WCB–Das menschliche Gehirn ist anfällig für Stress, Angst und Depressionen. Vektor-Illustration von psychischen Störungen.

RMW0H2W4–Präsident Barack Obama kündigt die Schaffung des Gehirns (das Gehirn Forschung durch die Förderung innovativer Neurotechnologies) Initiative, am 2. April 2013 im Weißen Haus in Washington, D.C. Die Initiative ist eine neue Forschung planen Sie neue Wege finden, zu behandeln, zu heilen und zu verhindern, dass Erkrankungen des Gehirns wie Alzheimer und Epilepsie. UPI/Kevin Dietsch

RM3AGRKAD–25. März 2012 - QA'em Shahr, Mazandaran, Iran - es gibt fast 90 Männer in diesem Zentrum, die an angeborenen oder zufälligen Gehirnerkrankungen leiden. Ein Großteil der Hilfe für diese Organisation wird öffentlich unterstützt. Dennoch hat die Organisation finanzielle Engpässe bei der Bereitstellung von Medikamenten und medizinischen Geräten. Zu den bemerkenswertesten Einrichtungen dieser Organisation gehören die gute Ernährung, Schlaf und Hygiene. Für diese psychisch gestörten Menschen gibt es Ausbildungszeiten wie Bildhauerei und Malerei. Die meisten von ihnen freuen sich immer auf ihre Familien und

RF2WDCT7J–Die Ärztin, Latina Neurologe, betreut männliche, brünette Patienten in ihrer Praxis, zeigt eine Röntgenaufnahme des Gehirns, um Kopfverletzungen und Gehirnerkrankungen zu beurteilen

RF2N1N3HG–Gehirn und DNA als Gene, die mit Genmutationen verbunden sind, die für neurologische oder psychische Störungen und die Entwicklung des Denkorgans verantwortlich sind

RF3DBM791–Kinderbau Holzblockturm: Therapeutisches Spiel für kognitive und motorische Entwicklung. Aktivitäten für Kinder mit psychischen Störungen. Hirnentwicklung

RF2XAHGD8–Menschliches Gehirn, chemische und molekulare Strukturen gegen Datenverarbeitung und Grünlichtwege

RFRCP6KT–Symbol für die Welt Parkinson Tag. Vector Illustration. Grau awareness Ribbon, auf weißem Hintergrund. Symbol des Gehirns

RMF1JY1K–Eine Frau in einer Arztpraxis wird unterzogen Elektroenzephalogramm (EEG) zur Erkennung von Anomalien in die elektrische Aktivität ihres Gehirns.
RMKP9GGN–Nervenzelle in einer Petrischale, Forschung zu Alzheimer und anderen Erkrankungen des Gehirns.

RM2YADPAW–Anatomie des menschlichen Gehirns Nervensystem, Nervenkrebs, Talgkolben, Hirnkrebs Tumorwachstum und Ausbreitung maligner Zellen, Meningeom, neurologisches d

RMJ3APHD–Eduard Hitzig war ein deutscher Psychiater und Neurologe im späten 19. Jahrhundert, bekannt für seine Pionierarbeit in der Hirnkartierung und neurologischen Forschung. Seine Arbeit konzentrierte sich auf die motorischen Bereiche des Gehirns und ihre Rolle bei der Bewegungskontrolle.

RF2YAR0NE–Darm-Hirn-Achse. Die Kommunikation zwischen Darm und Gehirn. Darmmikrobiota, Durchblutung, Vagusnerv und enterisches Nervensystem vom Gehirn zu

RM2JKFTJ5–Forscher haben Verbindungen zwischen Neuronen in Gehirnsystemen identifiziert, die mit Belohnung, Stress und Emotion assoziiert sind. Die neue Studie, die an Mäusen durchgeführt wurde, könnte dazu beitragen, mehrere psychiatrische Störungen zu entwirren, darunter Alkoholkonsumstörungen, Angststörungen, Schlaflosigkeit und Depressionen beim Menschen.

RMW0H2W7–Präsident Barack Obama kündigt die Schaffung des Gehirns (das Gehirn Forschung durch die Förderung innovativer Neurotechnologies) Initiative, am 2. April 2013 im Weißen Haus in Washington, D.C. Die Initiative ist eine neue Forschung planen Sie neue Wege finden, zu behandeln, zu heilen und zu verhindern, dass Erkrankungen des Gehirns wie Alzheimer und Epilepsie. UPI/Kevin Dietsch

RM3AGRKAM–25. März 2012 - QA'em Shahr, Mazandaran, Iran - es gibt fast 90 Männer in diesem Zentrum, die an angeborenen oder zufälligen Gehirnerkrankungen leiden. Ein Großteil der Hilfe für diese Organisation wird öffentlich unterstützt. Dennoch hat die Organisation finanzielle Engpässe bei der Bereitstellung von Medikamenten und medizinischen Geräten. Zu den bemerkenswertesten Einrichtungen dieser Organisation gehören die gute Ernährung, Schlaf und Hygiene. Für diese psychisch gestörten Menschen gibt es Ausbildungszeiten wie Bildhauerei und Malerei. Die meisten von ihnen freuen sich immer auf ihre Familien und

RF2WDCTAG–Die Ärztin, Latina Neurologe, betreut männliche, brünette Patienten in ihrer Praxis, zeigt eine Röntgenaufnahme des Gehirns, um Kopfverletzungen und Gehirnerkrankungen zu beurteilen

RF2BK9YB4–Menschliches Gehirn zerfällt oder auseinander 3D-Rendering-Illustration. Gedächtnisstörungen, neurologische Erkrankungen wie Parkinson oder Alzheimer, amn

RF2XHEM0K–Hirnstörung oder psychische Störungen Hirngesundheitskonzept als neurologisches Symbol oder psychiatrisches und psychologisches Symbol mit Zahnradfehlfunktion.

RF3DBM78Y–Kinderbau Holzblockturm: Therapeutisches Spiel für kognitive und motorische Entwicklung. Aktivitäten für Kinder mit psychischen Störungen. Hirnentwicklung

RM2RM0RXX–Bildnummer: 59468037 Datum: 02.04.2013 Copyright: imago/Xinhua (130402) -- WASHINGTON D.C., 2. April 2013 (Xinhua) -- US-Präsident Barack Obama nimmt an der Ankündigung der BRAIN-Initiative (Brain Research through Advancing innovative Neurotechnologies) der Regierung Teil, die am 2. April 2013 im East Room des Weißen Hauses in Washington D.C., der Hauptstadt der Vereinigten Staaten, stattfindet. Die Initiative soll das Verständnis des menschlichen Geistes revolutionieren und soll Forschern schließlich helfen, neue Wege zur Behandlung, Heilung und sogar Vorbeugung von Hirnerkrankungen zu finden. (Xinhua/Zhang Jun) US-WAS

RFRCP6AM–Symbol für die Welt Parkinson Tag. Vector Illustration. Grau awareness Ribbon, auf weißem Hintergrund. Symbol des Gehirns

RF2F8EEYA–Test Bestimmen Sie Schlafstörungen. Die Abbildung zeigt, dass EIN Mann die ganze Nacht durchgeschlafen hat, während das Körpern-System immer noch normal ist.

RMKP9GJ7–Nervenzelle in einer Petrischale, Forschung zu Alzheimer und anderen Erkrankungen des Gehirns.

RFE4KM0K–Silberne Schleife und Kalender mit markierten Tag. Symbol der Parkinson Erkrankung, Eierstock-Krebs, Erkrankungen des Gehirns und disabilit

RM2YADPT9–Anatomie des menschlichen Gehirns Nervensystem, Nervenkrebs, Talgkolben, Hirnkrebs Tumorwachstum und Ausbreitung maligner Zellen, Meningeom, neurologisches d

RMKCRH09–Seite 368 eines Textes mit dem Titel „Gehirn“ bietet Einblicke in die Neurowissenschaft, wobei der Schwerpunkt wahrscheinlich auf Gehirnfunktionen oder -Strukturen liegt. Das Buch oder die Forschungsstudie bietet wertvolle Informationen über die Anatomie und Physiologie des menschlichen Gehirns.

RF2PPWR9E–Menschliches Gehirn mit einem Teil des limbischen Systems und zerebraler Cortex, Suprachiasmatischer Nucleus, Chiasma opticum, Hypothalamus, Und die Zirbeldrüse

RMW0H2WB–Präsident Barack Obama kündigt die Schaffung des Gehirns (das Gehirn Forschung durch die Förderung innovativer Neurotechnologies) Initiative, am 2. April 2013 im Weißen Haus in Washington, D.C. Die Initiative ist eine neue Forschung planen Sie neue Wege finden, zu behandeln, zu heilen und zu verhindern, dass Erkrankungen des Gehirns wie Alzheimer und Epilepsie. UPI/Kevin Dietsch

RM3AGRKC2–25. März 2012 - QA'em Shahr, Mazandaran, Iran - es gibt fast 90 Männer in diesem Zentrum, die an angeborenen oder zufälligen Gehirnerkrankungen leiden. Ein Großteil der Hilfe für diese Organisation wird öffentlich unterstützt. Dennoch hat die Organisation finanzielle Engpässe bei der Bereitstellung von Medikamenten und medizinischen Geräten. Zu den bemerkenswertesten Einrichtungen dieser Organisation gehören die gute Ernährung, Schlaf und Hygiene. Für diese psychisch gestörten Menschen gibt es Ausbildungszeiten wie Bildhauerei und Malerei. Die meisten von ihnen freuen sich immer auf ihre Familien und

RF2WDCTDB–Die Ärztin, Latina Neurologe, betreut männliche, brünette Patienten in ihrer Praxis, zeigt eine Röntgenaufnahme des Gehirns, um Kopfverletzungen und Gehirnerkrankungen zu beurteilen

RFJ33W2N–junger Mann mit besorgt gestresster Gesichtsausdruck und Gehirn schmelzen in Linien Fragezeichen. Obsessive compulsive, ADHS, Angststörungen

RF2SPT407–Hippocampus Gehirn und Amygdala Anatomisches medizinisches Konzept als Teil des limbischen Systems in Verbindung mit sensorischen und motorischen Signalen im Nervensystem mit mu

RF3CN8WFE–Illustration des menschlichen Gehirns mit Hervorhebung des Gyrus cingulata, der für die Emotionsverarbeitung, Entscheidungsfindung und kognitive Kontrolle bei verschiedenen Störungen essentiell ist.





























